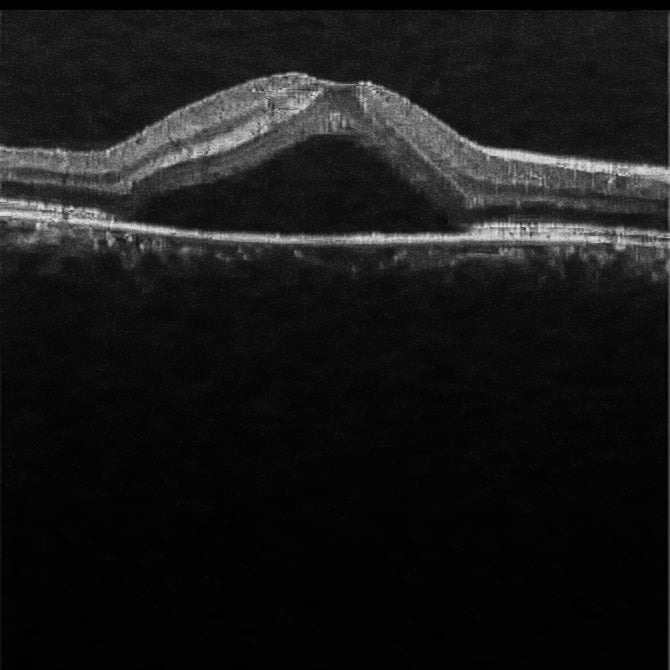
OCT Portátil IXANNER 7vn

OCT Portátil IXANNER 7vn
*PRECIO PUBLICADO SIN IVA / *PARA DESCUENTOS POR PROYECTO CONTACTARSE A ATENCION AL CLIENTE.
El OCT portátil IXanner® 7vn de MedevPlus está diseñado específicamente para el cribado ocular completo, abarcando los segmentos anterior y posterior, incluyendo la córnea, la cámara anterior (CA) y la retina (mácula y CNO). El producto ofrece diversas funciones seleccionables, como generación de enlaces, renderizado de volumen, medición del ángulo de la CA, grosor de la capa de fibras nerviosas de la retina (RNFL), mapas TSNI, análisis de glaucoma, CDR y DMAE, entre otras. El IXanner® 7vn es un dispositivo portátil pionero a nivel mundial, que permite su fácil transporte a cualquier lugar de la India y garantiza su compatibilidad con diversos entornos desinfectados.
- OCT portátil: IXanner® 7vn se rige como el único dispositivo OCT portátil a nivel mundial, abordando la creciente necesidad de soluciones de imágenes médicas convenientes. Su portabilidad le da una ventaja competitiva en el mercado, atendiendo a las cambiantes demandas de atención médica.
- Orgullosamente fabricado en la India: Adoptando el espíritu de "Hecho en la India", el IXanner® 7vn es el primer y único dispositivo OCT fabricado en la India. Esto refleja nuestro compromiso con la innovación local y los estándares de calidad inquebrantables.
GENERALFOCUS ES EL PRIMER DISTRIBUIDOR EXCLUSIVO EN LATAM
Ventajas clave
- Garantía de fabricación de 3 años: Ofreciendo tranquilidad, nuestra garantía de fabricación inclusiva de 3 años muestra nuestra confianza en la fiabilidad y durabilidad del producto, asegurando una asociación duradera.
- Aumente la rentabilidad y la precisión: La introducción de los escaneos IXanner® 7vn OCT a los centros primarios promete una mejora significativa del 35% tanto en la rentabilidad como en la precisión diagnóstica, alineada con los objetivos de los hospitales para mejorar los resultados de la atención al paciente.
- Información completa de datos: Más allá de las capacidades de imagen, IXanner® 7vn ofrece un análisis profundo de tejidos, equipando a los equipos médicos con conocimientos críticos para la detección temprana y tratamientos precisos.
- Integración de telemedicina: Integrándose sin problemas con las configuraciones de telemedicina, el dispositivo permite consultas remotas con imágenes en tiempo real, ampliando los horizontes de los servicios médico
-
Especificación 7vn Longitud de onda 840 nm Resolución axial 7 µm Velocidad de adquisición 13KHz, 40KHz, 80KHz Corrección de dioptrías '-16D a +16 D Potencia de salida en la muestra <=750 µW Profundidad de la imagen 2,7 milímetros SNR 1190dB Opciones de escaneo Línea, área, círculo, multilínea, escaneo largo y radial Telecentricidad 7 mm x 7 mm Resolución transversal <=15 µm FOV retiniana >= 45 Representación de volumen Mapas TSNI con grosor RNFL
Pairs well with
Despacho a todo Chile
Pago seguro
Distribución autorizada

OCT Portátil IXANNER 7vn
Si tiene alguna pregunta, no dude en contactarnos. Le responderemos lo antes posible, en un plazo de 24 horas entre semana.
-
Shipping Information
Use this text to answer questions in as much detail as possible for your customers.
-
Information
Share contact information, store details, and brand content with your customers.
-
Customer Support
Use this text to answer questions in as much detail as possible for your customers.
-
FAQ’s
Use this text to answer questions in as much detail as possible for your customers.
-
Contact Us
Use this text to answer questions in as much detail as possible for your customers.

